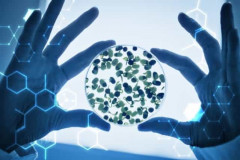

ԱՄԵՆԱԸՆԹԵՐՑՎԱԾ
 Ընտանիքը լքած հայրը, տեսնելով կնոջ արցունքները, վերադարձել է տուն | տեսանյութ
Ընտանիքը լքած հայրը, տեսնելով կնոջ արցունքները, վերադարձել է տուն | տեսանյութ
 Ինչ է պատմում քո աչքերի գույնը քո մասին
Ինչ է պատմում քո աչքերի գույնը քո մասին
 Բացառիկ կադրեր հայկական «Սկադ» մահաբեր հրթիռներից. (տեսանյութ)
Բացառիկ կադրեր հայկական «Սկադ» մահաբեր հրթիռներից. (տեսանյութ)
 Եզակի պահպանված հարցազրույց Մհեր Մկրտչյանի հետ
Եզակի պահպանված հարցազրույց Մհեր Մկրտչյանի հետ
 15 միլիոնից ավելի դիտում. երիտասարդի և իր ընկերուհու խենթությունները՝ համացանցի ...
15 միլիոնից ավելի դիտում. երիտասարդի և իր ընկերուհու խենթությունները՝ համացանցի ...
 Գոռացին` վատ է, մինչեւ ջուր հասցրինք, մահացել էր. մանրամասներ երթուղայինում տղամ...
Գոռացին` վատ է, մինչեւ ջուր հասցրինք, մահացել էր. մանրամասներ երթուղայինում տղամ...
 Սեր, սեքս և ուտելիք՝ ահա այն ամենը, ինչը մեզ իրոք երջանկացնում է. Մերիլ Սթրիփի կ...
Սեր, սեքս և ուտելիք՝ ահա այն ամենը, ինչը մեզ իրոք երջանկացնում է. Մերիլ Սթրիփի կ...
 Դերասանը ծաղրում է վարչապետին (տեսանյութ)
Դերասանը ծաղրում է վարչապետին (տեսանյութ)
 Ում առաջարկով և ինչպես է ստեղծվել Լիլիթ Հովհաննիսյանի և Կամիլի զուգերգը
Ում առաջարկով և ինչպես է ստեղծվել Լիլիթ Հովհաննիսյանի և Կամիլի զուգերգը
 Տաքսու վարորդի սպանության բացահայտումը. մանրամասներ (ՏԵՍԱՆՅՈՒԹ)
Տաքսու վարորդի սպանության բացահայտումը. մանրամասներ (ՏԵՍԱՆՅՈՒԹ)
 Գարիկ Մարտիրոսյանը` ՀՀ նախագահ. Տեսանյութ
Գարիկ Մարտիրոսյանը` ՀՀ նախագահ. Տեսանյութ
 Չարությանն ՝ ըմբռնումով, բարությանը ՝ վստահությամբ. Արփինե Հովհաննիսյանի «Կյանքը...
Չարությանն ՝ ըմբռնումով, բարությանը ՝ վստահությամբ. Արփինե Հովհաննիսյանի «Կյանքը...
 Երեւանում երթուղային տաքսու մեջ տղամարդ է հանկարծամահ եղել
Երեւանում երթուղային տաքսու մեջ տղամարդ է հանկարծամահ եղել
 Ակնհայտ է, որ լինելու է քսակների կռիվ՝ զոռբայության մթնոլորտում. Ռոբերտ Քոչարյան
Ակնհայտ է, որ լինելու է քսակների կռիվ՝ զոռբայության մթնոլորտում. Ռոբերտ Քոչարյան
 Ինչու է Հայկ Պետրոսյանը «X Factor»-ում փոխարինել Գրիշա Աղախանյանին
Ինչու է Հայկ Պետրոսյանը «X Factor»-ում փոխարինել Գրիշա Աղախանյանին
 Իմ եղբոր հետ ի՞նչ կապ ունի ինքը, ղալաթ ա անում. Սուրիկ Խաչատրյանը՝ Գորիսի միջադե...
Իմ եղբոր հետ ի՞նչ կապ ունի ինքը, ղալաթ ա անում. Սուրիկ Խաչատրյանը՝ Գորիսի միջադե...
 Ցավում եմ, որ մարդկանց մեջ այսքան ատելություն կա. Ռոլանդ Գասպարյանը` ՀՀԿ-ի քարոզ...
Ցավում եմ, որ մարդկանց մեջ այսքան ատելություն կա. Ռոլանդ Գասպարյանը` ՀՀԿ-ի քարոզ...
 ՔԱՔ-ը ձեզ հետ կլինի նաև անդրշիրիմյան կյանքում. Սերգեյ Դանիելյան
ՔԱՔ-ը ձեզ հետ կլինի նաև անդրշիրիմյան կյանքում. Սերգեյ Դանիելյան
 Խոշոր սուպերմարկետները ժամը 21-ից հետո փակվելու են, 18 տարեկանները առաջնագիծ չեն...
Խոշոր սուպերմարկետները ժամը 21-ից հետո փակվելու են, 18 տարեկանները առաջնագիծ չեն...
 22-ամյա հայուհին «Սարերի հովին մեռնեմ» երգով ստիպել է«Голос»-ի մարզիչներին արտասվել
22-ամյա հայուհին «Սարերի հովին մեռնեմ» երգով ստիպել է«Голос»-ի մարզիչներին արտասվել
 «Ծառուկյան» դաշինքը նախընտրական քարոզարշավը սկսեց սահմանամերձ Տավուշի մարզից (տե...
«Ծառուկյան» դաշինքը նախընտրական քարոզարշավը սկսեց սահմանամերձ Տավուշի մարզից (տե...
 Նոր մանրամասներ` «Ճվճվ Արոյի» որդու հետ կատարվածից. ինչ կապ ունի նրանց հետ պայծա...
Նոր մանրամասներ` «Ճվճվ Արոյի» որդու հետ կատարվածից. ինչ կապ ունի նրանց հետ պայծա...
 «Նա Աջափնյակում մեծ կարողություններ ունի». Գալուստ Սահակյանը՝ ՀՀԿ-ի ցուցակով առա...
«Նա Աջափնյակում մեծ կարողություններ ունի». Գալուստ Սահակյանը՝ ՀՀԿ-ի ցուցակով առա...
 8 մթերք, որոնք արագացնում են նյութափոխանակությունը
8 մթերք, որոնք արագացնում են նյութափոխանակությունը
 երգը հայերեն թարգմանությամբ
երգը հայերեն թարգմանությամբ
 Հետաքրքիր և միևնույն ժամանակ զարմանալի փաստեր մարդու մասին
Հետաքրքիր և միևնույն ժամանակ զարմանալի փաստեր մարդու մասին
 Անժելա Սարգսյանի՝ երբևէ չհրապարակած սեքսուալ լուսանկարները (ֆոտոշարք)
Անժելա Սարգսյանի՝ երբևէ չհրապարակած սեքսուալ լուսանկարները (ֆոտոշարք)
 Ես ընկալվում էի որպես ոչ լուրջ երգչուհի, բայց իրենց «ինադու» առաջ գնացի. Ալլա Լև...
Ես ընկալվում էի որպես ոչ լուրջ երգչուհի, բայց իրենց «ինադու» առաջ գնացի. Ալլա Լև...
 Առաջատարը «Ծառուկյան» դաշինքն է. Gallup International Association
Առաջատարը «Ծառուկյան» դաշինքն է. Gallup International Association
 Արցախում 3,4 մագնիտուդ ուժգնությամբ երկրաշարժ է տեղի ունեցել
Արցախում 3,4 մագնիտուդ ուժգնությամբ երկրաշարժ է տեղի ունեցել
 ՊԱՏՄՈՒԹՅԱՆ ԱՅՍ ՕՐԸ
ՊԱՏՄՈՒԹՅԱՆ ԱՅՍ ՕՐԸ
 Գերմանիայի Նաուբուրգ քաղաքում բացվել է Արմավիրի ծառուղի
Գերմանիայի Նաուբուրգ քաղաքում բացվել է Արմավիրի ծառուղի
 ԱՄՆ-ը կխթանի Հնդկաստանի և Վենեսուելայի միջև էներգետիկ համագործակցությունը. Ռուբիո
ԱՄՆ-ը կխթանի Հնդկաստանի և Վենեսուելայի միջև էներգետիկ համագործակցությունը. Ռուբիո Բալթյան երկրները Եվրամիությանը կոչ են արել հնարավորինս շուտ ներկայացնել ռուսական նավթից լիակատար հրաժարվելու ծրագիրը․ FT
Բալթյան երկրները Եվրամիությանը կոչ են արել հնարավորինս շուտ ներկայացնել ռուսական նավթից լիակատար հրաժարվելու ծրագիրը․ FT Վիճաբանություն և ծեծկռտուք՝ Արարատի մարզում. 4 անձ է ձերբակալվել
Վիճաբանություն և ծեծկռտուք՝ Արարատի մարզում. 4 անձ է ձերբակալվել Ոչնչացվել է 25 տոննա մսամթերք. ՍԱՏՄ
Ոչնչացվել է 25 տոննա մսամթերք. ՍԱՏՄ Ադրբեջանական լրատվամիջոցները հիստերիայի մեջ են ընկել ռուսական հեռուստաալիքի ռեպորտաժում Արցախի դրոշով թևանշանի պատճառով
Ադրբեջանական լրատվամիջոցները հիստերիայի մեջ են ընկել ռուսական հեռուստաալիքի ռեպորտաժում Արցախի դրոշով թևանշանի պատճառով Ինչպես է Զիգմունդ Ֆրոյդի թոռը հոգնած պետական ծառայողին վերածել 39 միլիոն դոլար արժողությամբ գլուխգործոցի
Ինչպես է Զիգմունդ Ֆրոյդի թոռը հոգնած պետական ծառայողին վերածել 39 միլիոն դոլար արժողությամբ գլուխգործոցի  Վրաստանում թմրամիջոցների մաքսանենգության և իրացման գործով Թուրքիայի և Ճապոնիայի քաղաքացիներ են ձերբակալվել
Վրաստանում թմրամիջոցների մաքսանենգության և իրացման գործով Թուրքիայի և Ճապոնիայի քաղաքացիներ են ձերբակալվել Պայծառ կապույտ մազեր և փիրսինգ. Նորթ Ուեսթը զարմացրել է Փարիզի նորաձևության շաբաթվա հանդիսատեսին
Պայծառ կապույտ մազեր և փիրսինգ. Նորթ Ուեսթը զարմացրել է Փարիզի նորաձևության շաբաթվա հանդիսատեսին Մեսսին Հորդանանի դեմ խաղը կսկսի պահեստայինների նստարանից
Մեսսին Հորդանանի դեմ խաղը կսկսի պահեստայինների նստարանից
 ԱՄՆ ԶՈւ-ն հայտնել են Իրանին hարվածելու մասին
ԱՄՆ ԶՈւ-ն հայտնել են Իրանին hարվածելու մասին
 Փամբակ գետում հայտնաբերվել է մարմին
Փամբակ գետում հայտնաբերվել է մարմին
 ՀՀ ազգային հավաքականի նախկին գլխավոր մարզիչի մոտ ախտորոշվել է հաստ աղիքի քաղցկեղ
ՀՀ ազգային հավաքականի նախկին գլխավոր մարզիչի մոտ ախտորոշվել է հաստ աղիքի քաղցկեղ
 Ս. Տրդատ թագավորի, Աշխեն թագուհու և Խոսրովիդուխտ կույսի հիշատակության օրն է այսօր
Ս. Տրդատ թագավորի, Աշխեն թագուհու և Խոսրովիդուխտ կույսի հիշատակության օրն է այսօր
 TRIPP նախագծի իրականացման արժեքը․ ֆինանսների փոխնախարարը մանրամասնում է
TRIPP նախագծի իրականացման արժեքը․ ֆինանսների փոխնախարարը մանրամասնում է
 Արենիի ավագ սերնդի ներկայացուցիչներն այսուհետ ունեն ժամանցի նոր վայր. դռներն է բացել «Գտնված երազ» երկրորդ ակումբը
Արենիի ավագ սերնդի ներկայացուցիչներն այսուհետ ունեն ժամանցի նոր վայր. դռներն է բացել «Գտնված երազ» երկրորդ ակումբը
 Հային հայո՞վ․ Կրասնոդարը որոշել է Սպերցյանի հավանական փոխարինողին
Հային հայո՞վ․ Կրասնոդարը որոշել է Սպերցյանի հավանական փոխարինողին
 Փրկարարները Փամբակ գետում հայտնաբերել են ավտոմեքենա և տղամարդու դի
Փրկարարները Փամբակ գետում հայտնաբերել են ավտոմեքենա և տղամարդու դի
 Արտակարգ դեպք՝ Երևանում. հաջողվել է փրկել 3 քաղաքացիների կյանքը
Արտակարգ դեպք՝ Երևանում. հաջողվել է փրկել 3 քաղաքացիների կյանքը Հայոց ցեղասպանության զոհերի հուշահամալիրի բարեկարգումը կավարտվի դեկտեմբերին. նախարար
Հայոց ցեղասպանության զոհերի հուշահամալիրի բարեկարգումը կավարտվի դեկտեմբերին. նախարար
 Պուտինը ստորագրել է միգրանտների համար տուրքերը 5-12 անգամ բարձրացնելու մասին օրենքը
Պուտինը ստորագրել է միգրանտների համար տուրքերը 5-12 անգամ բարձրացնելու մասին օրենքը
 Վենեսուելայում երկրաշարժի հետևանքով մաhացել է առնվազն 920 մարդ
Վենեսուելայում երկրաշարժի հետևանքով մաhացել է առնվազն 920 մարդ
 Իրանը պնդում է, որ ԱՄՆ-ն խախտել է հակամարտության կարգավորման վերաբերյալ հուշագրի 2 կետ
Իրանը պնդում է, որ ԱՄՆ-ն խախտել է հակամարտության կարգավորման վերաբերյալ հուշագրի 2 կետ
 Անձրևները կլինեն հորդառատ
Անձրևները կլինեն հորդառատ Վիճաբանություն և ծեծկռտուք՝ Արարատի մարզում
Վիճաբանություն և ծեծկռտուք՝ Արարատի մարզում Ղրիմում խոշոր անտառային հրդեհ է բռնկվել
Ղրիմում խոշոր անտառային հրդեհ է բռնկվել
 Հարավային Կորեան հայտարարել է, որ իր օդային պաշտպանության գոտում հայտնաբերել է 10 ռուսական և չինական ինքնաթիռներ
Հարավային Կորեան հայտարարել է, որ իր օդային պաշտպանության գոտում հայտնաբերել է 10 ռուսական և չինական ինքնաթիռներ
 Փոխվել է դրոշմանիշային վճարի ավելի վճարված գումարի վերադարձի կարգը. ի՞նչ է փոխվում
Փոխվել է դրոշմանիշային վճարի ավելի վճարված գումարի վերադարձի կարգը. ի՞նչ է փոխվում Սահմանադրական դատարանը միաձայն մերժել է «Միասնության թևեր»-ի դիմումը
Սահմանադրական դատարանը միաձայն մերժել է «Միասնության թևեր»-ի դիմումը
 Սյունիքում «Mercedes-Benz» կցորդով բեռնատարը կողաշրջվել է․ վարորդը տեղափոխվել է հիվանդանոց
Սյունիքում «Mercedes-Benz» կցորդով բեռնատարը կողաշրջվել է․ վարորդը տեղափոխվել է հիվանդանոց
 Փամբակ գետում հայտնաբերվել է մարմին. փրկարարները հատուկ ճոպանների միջոցով փորձում են դուրս բերել ափ
Փամբակ գետում հայտնաբերվել է մարմին. փրկարարները հատուկ ճոպանների միջոցով փորձում են դուրս բերել ափ
 Ուկրաինայում նշվել է Աստվածածնի հայկական պատկերակի օրվա 235-ամյակը
Ուկրաինայում նշվել է Աստվածածնի հայկական պատկերակի օրվա 235-ամյակը
 Գերմանիան ու Ֆրանսիան իմացել են իրենց մրցակիցներին ԱԱ-2026-ի փլեյ-օֆֆում
Գերմանիան ու Ֆրանսիան իմացել են իրենց մրցակիցներին ԱԱ-2026-ի փլեյ-օֆֆում
 Տարադրամի փոխարժեքները` այսօր
Տարադրամի փոխարժեքները` այսօր Խոշոր ավտովթար Լոռու մարզում
Խոշոր ավտովթար Լոռու մարզում Նախկին պատգամավոր. Լատվիան չի փոխարինի Ռուսաստանի շուկան Հայաստանի համար
Նախկին պատգամավոր. Լատվիան չի փոխարինի Ռուսաստանի շուկան Հայաստանի համար
 Հայերը պնդում են, որ Ռուսաստանի հետ հարաբերությունների խզման պատճառով իրենց երկիրը վերածվում է թուրքական բենզալցակայանի
Հայերը պնդում են, որ Ռուսաստանի հետ հարաբերությունների խզման պատճառով իրենց երկիրը վերածվում է թուրքական բենզալցակայանի Գալիս են «փրկելու». գործող իշխանությունը կշարունակի՞ հակառուսական ուղղությունը. «Փաստ»
Գալիս են «փրկելու». գործող իշխանությունը կշարունակի՞ հակառուսական ուղղությունը. «Փաստ» Վրաստանի համար ի՞նչ կնշանակի Ռուսաստանի և Հայաստանի միջև բեռնափոխադրումների կրճատումը
Վրաստանի համար ի՞նչ կնշանակի Ռուսաստանի և Հայաստանի միջև բեռնափոխադրումների կրճատումը Արևմտյան աջակցության արդյունքը՝ ժողովրդավարության ոչնչացում, բռնաճնշումներ, հետապնդումներ. «Փաստ»
Արևմտյան աջակցության արդյունքը՝ ժողովրդավարության ոչնչացում, բռնաճնշումներ, հետապնդումներ. «Փաստ» Արդյո՞ք Էրդողանը կգրավի Հայաստանը Եվրոպայի փոխարեն. Փաշինյանին չեն ներելու. Ռուսաստանից հեռանալը թանկ կարժենա
Արդյո՞ք Էրդողանը կգրավի Հայաստանը Եվրոպայի փոխարեն. Փաշինյանին չեն ներելու. Ռուսաստանից հեռանալը թանկ կարժենա Մահացել է ՀՀ ժողովրդական արտիստ Ռաիսա Մկրտչյանը
Մահացել է ՀՀ ժողովրդական արտիստ Ռաիսա Մկրտչյանը Էլեկտրաէներգիայի ընդհատումներ կլինեն Երևանում և մարզերում․ հասցեներ
Էլեկտրաէներգիայի ընդհատումներ կլինեն Երևանում և մարզերում․ հասցեներ
 «Մեր ապրելու ուժը Նարեկին ապրեցնելն է». հրետանավոր Նարեկ Սահակյանն անմահացել է հոկտեմբերի 26-ին Մարտունիում. «Փաստ»
«Մեր ապրելու ուժը Նարեկին ապրեցնելն է». հրետանավոր Նարեկ Սահակյանն անմահացել է հոկտեմբերի 26-ին Մարտունիում. «Փաստ» Արցախյան առաջին պատերազմի ժամանակ հայկական զինված ուժերը գրավել են Մարտակերտ քաղաքը. պատմության այս օրը (27 հունիս)
Արցախյան առաջին պատերազմի ժամանակ հայկական զինված ուժերը գրավել են Մարտակերտ քաղաքը. պատմության այս օրը (27 հունիս) Հստակեցումներ կարվեն արտադպրոցական ծրագրերի իրականացման գործընթացում. ի՞նչ գործնական խնդիրներ են ի հայտ եկել. «Փաստ»
Հստակեցումներ կարվեն արտադպրոցական ծրագրերի իրականացման գործընթացում. ի՞նչ գործնական խնդիրներ են ի հայտ եկել. «Փաստ» ՔՊ-ն ամենաբարձր արդյունքը գրանցել է Վայոց Ձորի մարզում. «Ժողովուրդ»
ՔՊ-ն ամենաբարձր արդյունքը գրանցել է Վայոց Ձորի մարզում. «Ժողովուրդ»
 Ամառային զորակոչից առաջ Էդվարդ Ասրյանը ստուգել է հանրապետական հավաքակայանի պատրաստվածությունը
Ամառային զորակոչից առաջ Էդվարդ Ասրյանը ստուգել է հանրապետական հավաքակայանի պատրաստվածությունը
 Նիկոլ Փաշինյանը մամուլի նոր խոսնակ կունենա. «Հրապարակ»
Նիկոլ Փաշինյանը մամուլի նոր խոսնակ կունենա. «Հրապարակ»
ՔՊ-ում պաշտոնների կռիվ է․ «Հրապարակ»
ՔՊ-ում պաշտոնների կռիվ է․ «Հրապարակ»
